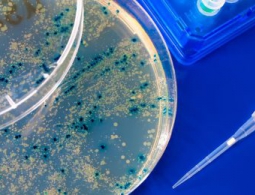
Бактериофаги: вирусы, которые могут спасти человечество

Приамурские ученые научились добывать золото из угля
БЛАГОВЕЩЕНСК, 21 ноя — РИА Новости. Ученые Амурского научного центра Дальневосточного отделения РАН научились извлекать из каждой тонны сжигаемого в котельных угля до одного грамма золота; экспериментальная установка уже создана, ее планируют внедрить на одной из котельных в 2017 году, сообщае...
Прибытие: как мы будем общаться с инопланетянами, если они пожалуют?
В фильме «Прибытие», который недавно вышел на экранах кинотеатров, на Землю прилетает двенадцать инопланетных кораблей. Инопланетяне — семиногие создания «гектаподы» — позволяют нескольким людям взойти на борт и поговорить, но никакого универсального пер...
Почему в самолетах так плохо кормят?
Итак, вы в самолете. Перед вами блюдо, которое только-только принесли. Но вместо долгожданного обеда на вас смотрит нечто ужасное. И это не всегда вина шеф-повара, всё немного сложнее.Еду разогреваютК тому, что путешествие происходит не на земле, а в воздухе, добавим непростое строение самол...
Создана капсула с лекарством, которая действует на протяжении двух недель
Согласитесь, болеть никто не любит. Но когда нас сражает недуг, мы принимаем лекарства, которых сейчас очень много, для того чтобы выздороветь. В этом случае мы четко соблюдаем режим, дабы побыстрее поправиться. Но многие ли столь же неукоснительно придерживаются режима приема, когда препараты нужно...
Ученые разработали способ выращивания искусственных мини-органов из особого гидрогеля
Проблема выпуска новых лекарственных средств на рынок стоит в последнее время особенно остро. Конечно, существует масса клинических исследований, но весь этот процесс достаточно долгий и трудоемкий. Одним из наиболее инновационных способов испытаний является использование мини-органов, которые доста...
Под ледяным «сердцем» Плутона, скорее всего, огромный океан
На днях астрономы представили лучшие на данный момент доказательства существования океана в неожиданном месте — на карликовой планете Плутон, в темных глубинках Солнечной системы. Там, где азот и другие летучие газы замерзают, а вода превращается в твердый как камень лед. Десятки лет учен...
Мышей омолодили инъекциями человеческой плазмы крови
В последнее время разговоров об омоложении организма не «снаружи», при помощи оперативного вмешательства и различных инъекций красоты, а «изнутри» говорят все чаще. Ученые ставят эксперименты с использованием стволовых клеток. Но компания Alkahest пошла несколько иным путем и...
Пациентам с облысением вернули волосы с помощью препарата от ревматоидного артрита
Облысение (или, по-научному, алопеция) — это состояние, при котором в силу разных причин человек начинает терять волосяной покров. Причем в некоторых случаях происходит потеря волос по всему телу, вплоть до выпадения бровей и ресниц. Конечно, алопеция не является жизнеугрожающим состоянием, но...
Вы купились на миф о спортивных напитках
“Не меньше восьми стаканов воды в день! Протеиновые коктейли! Спортивные напитки!”, — нас бомбардируют сообщениями о том, что и когда мы должны пить. Особенно достается тем, кто занимается физическими упражнениями всерьез. Но эти “питьевые истины” относительно новые. А...
Бактериофаги: вирусы, которые могут спасти человечество
В начале 1890-х годов Эрнест Ханкин изучал вспышки холеры возле берегов Ганга. Местные жители сбрасывали мертвых в воды священной реки, а река в ответ становилась ядовитым источником болезни, и эпидемия буйствовала в городах и деревнях вниз по речной долине. Он видел это по всей Европе, когда запасы...
Каждый мозг обладает «уникальным идентификационным отпечатком»
Люди часто говорят: «у разных людей мозг работает по-разному». Команда ученых под руководством исследователей из Университета Карнеги — Меллон недавно доказали это в буквальном смысле. Исследователи разработали способ «снятия отпечатков» человеческого мозга с использова...
В Индии запретили эксперимент по оживлению человеческого мозга
Индийский хирург-ортопед, сотрудник одной из больниц штата Уттаракханд, ещё в мае 2016 года объявил о том, что вместе с компанией Bioquark из Калифорнии собирается провести интересный эксперимент, в ходе которого учёные попытаются выяснить, возможна ли частичная регенерация мозга погибшего...